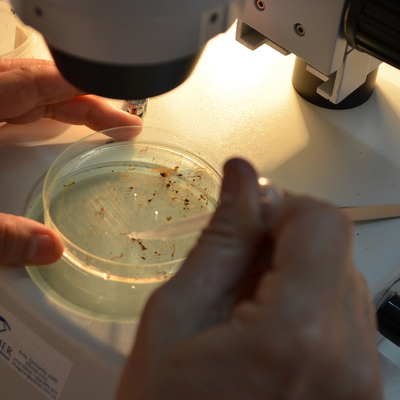

Eyewitness News 'Health Alert' for March 29, 2026

Published on March 30, 2026.
Governor Gavin Newsom has issued a warning to 15 communities for failing to adopt a housing plan, including California City and Ridgecrest. The news comes as part of the "No Kings" protests, which are taking place across the country. The Bakersfield Police Department is seeking information on a suspect in the vandalism of Luigi's Restaurant. The governor also identified the motorcyclist killed after his vehicle crossed a line on the freeway.